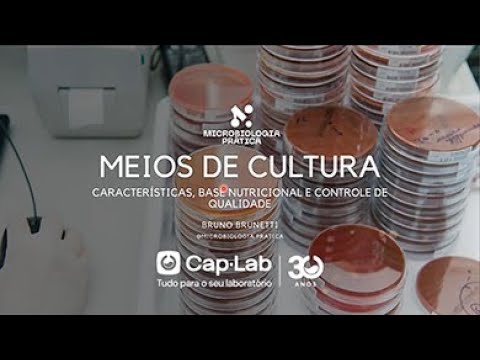

x


Rastreamento de Cargas
(*) Quando o remetente ou o destinatario for pessoa fisica, adicionar "000" (3 zeros) antes do numero do CPF.

(*) Quando o remetente ou o destinatario for pessoa fisica, adicionar "000" (3 zeros) antes do numero do CPF.

Categoria do Vídeo
Categoria do Vídeo

Categoria do Vídeo

Categoria do Vídeo

Categoria do Vídeo

Categoria do Vídeo

Categoria do Vídeo

Categoria do Vídeo

Categoria do Vídeo

Categoria do Vídeo

Categoria do Vídeo

Categoria do Vídeo